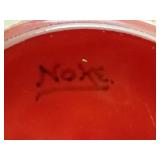
1920s Royal Douton Flambe

View current listings by this company
ROYAL CHRISTMAS ONLINE AUCTION
Listing ID#: 153086
| Sale Location |
|---|
|
DUNCAN, SC 29334 |
| Sale Dates and Times |
|---|
|
Bidding Starts: Tuesday Dec 12, 09:00 AM Bidding Ends: Wednesday Jan 3, 08:00 PM |
| Sale Type |
|---|
 Online Auction
VIEW ONLINE CATALOG Online Auction
VIEW ONLINE CATALOG |

| Company Information |
|---|
|
Caring Transitions of Upstate SC Contact: Donna Sherer Phone: 864-228-7573 Email: dsherer@caringtransitions.com Website: www.CaringTransitionsofUpstateSC.com EstateSale.com ID#: 4867 View company information and listings |
Free Email Notifications
Sign up for the EstateSale.com email notifications and we will let you know about sales in your area! You may set up alerts by area (zip and radius), keywords, and by company. It is FREE and only takes a few seconds to sign up.
| Listing Terms and Conditions |
|---|
|
1. All bidding begins at $1.00
2. There are No Reserves 3. This (1 & 2 above) yields true value for buyers 4. Bidding is 24 hours a day 5. It is underway NOW! 6. It is FUN! Follow this sale! There is so much value you are sure to be rewarded. |
| Listing Information |
|---|
|
Wonderful Christmas Liquidation... ROYAL CHRISTMAS ONLINE AUCTION Underway Now 24/7 Preview for this sale: If you are interested in attending Tuesday's Preview (in Duncan) held from 2-6 PM call or email to let us know. We must have the names of all planning to attend. No children under the age of 18. Bidding started at $1.00--No Reserves! Fit for a king, ROYAL CHRISTMAS ONLINE AUCTION is located in DUNCAN, SC 29334. This sale ends Wednesday, January 3rd. Pick-up starts at 9 AM, Thursday, December 7th. They immigrated from Stoke-On-Trent, Staffordshire, England: the birthplace of the world famous English Potteries and Fine China makers. In the late 19th century Royal Doulton became the most prestigious name among all the greats. Our client sought out rare pieces and low number limited editions. He was a serious collector of Old and Vintage Royal Doulton. Santa has arrived, his bag loaded with Heirloom Quality possessions in pristine, like-new condition. It's called the ROYAL CHRISTMAS ONLINE AUCTION. Examples are: · Rare Charles Noke 1920s Flambe Sung Ware Pottery · Henkel Harris Mahogany Furniture (Henkel Harris holds its value) · English Yew Wood & Mahogany Chippendale Furniture · Flawless Sets of English Fine China: Royal Doulton, Minton's Haddon Hall, Royal Albert, Royal Crown Derby, Coalport · Mission Audio-Stereo System w/Two Quad Speakers ...just to name a few. The Queen Henkel Harris Mahogany Bed retails for more than $10,000.00, and we have offered it at a starting bids of $1.00. There are dozens of similar bargain opportunities. Shop the ROYAL CHRISTMAS ONLINE AUCTION for Christmas. Unique & Hard To Find · Charleston Battery Cast Iron & Cypress Benches--Cast Iron made from Original Molds · Zero Halliburton Luggage · Thomas Russell & Sons Gold Pocket Watch--Antique Liverpool · Sculpted Translucent Limestone Framed Relief by C.F. Becker--France · Silk Brocade Handmade Sofa for small persons--Two of them--Pristine Condition · Vintage 1950s Bolex Paillard Movie Camera & Projector--eBay's for $900.00+ · Chippendale English Settee · 5 Different 1920s Royal Doulton Flambe Vases Valued at $1000 to $2000 · Royal Doulton Noke Designed Loving Cups · Vintage Baccarat French Crystal--Flawless Sets w/Original Boxes · Denby & Spinks English Regency Chairs and French Rococo Chairs--Like New · World War I Trench Art · English Yew Wood, Mahogany Wood, Cherry Wood Finely Crafted Furniture · French Limestone Relief Framed · Exotic Wooden Lacquered Cigar Boxes w/Delacroix Art · Moorcroft Pottery Lamps & Stiffel Lamps · Rosewood Attache Case Check it out now, and if you are new to us you are in for a treat. Our buyers love the Caring Transitions Way of selling. More fun and greater value. Our sales are ALL online. This sale is underway right now and runs continuously until it ends December 5th at 8 PM. It is essential to know the following: 1. All bidding begins at $1.00 2. There are No Reserves 3. This (1 & 2 above) yields true value for buyers 4. Bidding is 24 hours a day 5. It is underway NOW! 6. It is FUN! Follow this sale! There is so much value you are sure to be rewarded. HERE IS HOW TO GET TO THE AUCTION Click this link: ROYAL CHRISTMAS ONLINE AUCTION or, call (864) 243-8805 for help. QUESTIONS about the auction??? Please read the following... If you have time sensitive questions about the auction the best way to get an answer is to call (864)243-8805. If calling about an item in the auction please have the following information available: The Page Number that the item is on, and the Lot Number. We answer emailed questions as we have time. I am sorry to say that often times we don't get questions answered before the auction ends. We simply run out of time. Therefore, call (864) 243-8805 with questions related to the about items if the auction. We always get back to callers quickly when we miss calls, however most of the time we answer the phone. If we miss your call please leave a detailed message so that we can have the answer for you when we call back. As always, we welcome your comments and feedback. We appreciate you interest in our sales. Thank you, Rick & Janet Parkinson & the Caring Transitions Team (864) 243-8805
RParkinson@CaringTransitions.net |
|
Photo Gallery
|
|||||
|---|---|---|---|---|---|
|
|||||